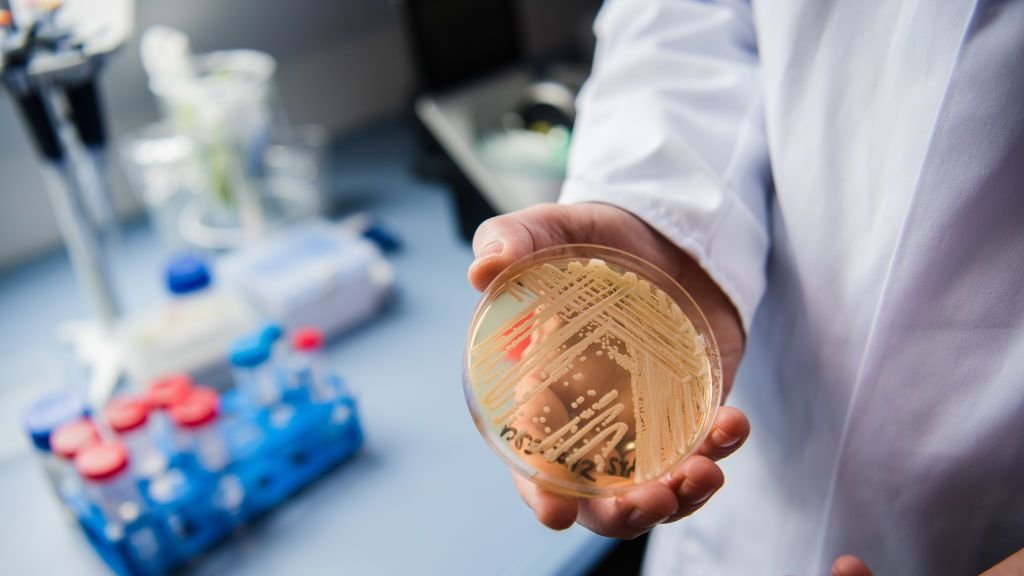

Kanadyjska choroba grzybiczna stwarza coraz większe zagrożenie dla zdrowia mieszkańców Stanów Zjednoczonych – poinformowały Krajowe Centra Kontroli i Prewencji chorób (CDC). Dodały, że wykryto ją już w ponad połowie stanów. Candida auris, czyli C. auris niepokoi lekarzy, ponieważ często jest odporna na leki przeciwgrzybicze, co utrudnia leczenie infekcji. Może być również trudna do zidentyfikowania za pomocą standardowych badań laboratoryjnych. Grzyb został po raz pierwszy wykryty w USA w 2016 roku. W alarmującym tempie rozprzestrzeniał się w latach 2020-2021 w placówkach służby zdrowia. W ciągu ostatnich dwunastu miesięcy w Illinois wykryto 276 przypadków zakażenia tym grzybem. Najwięcej, bo 384 potwierdzono w Nevadzie. Candida auris może dostać się do krwiobiegu i rozprzestrzeniać się po całym organizmie, potencjalnie prowadząc do poważnych i inwazyjnych infekcji – ostrzega CDC. Jest on szczególnie niebezpieczny dla osób z osłabionym układem immunologicznym a także zmagających się z chorobami nowotworowymi. CDC ostrzega, że w niektórych przypadkach infekcja może doprowadzić nawet do zgonu.
CDC ostrzega przed chorobą grzybiczną. W Illinois potwierdzono już ponad 200 przypadków
22 marca 2023